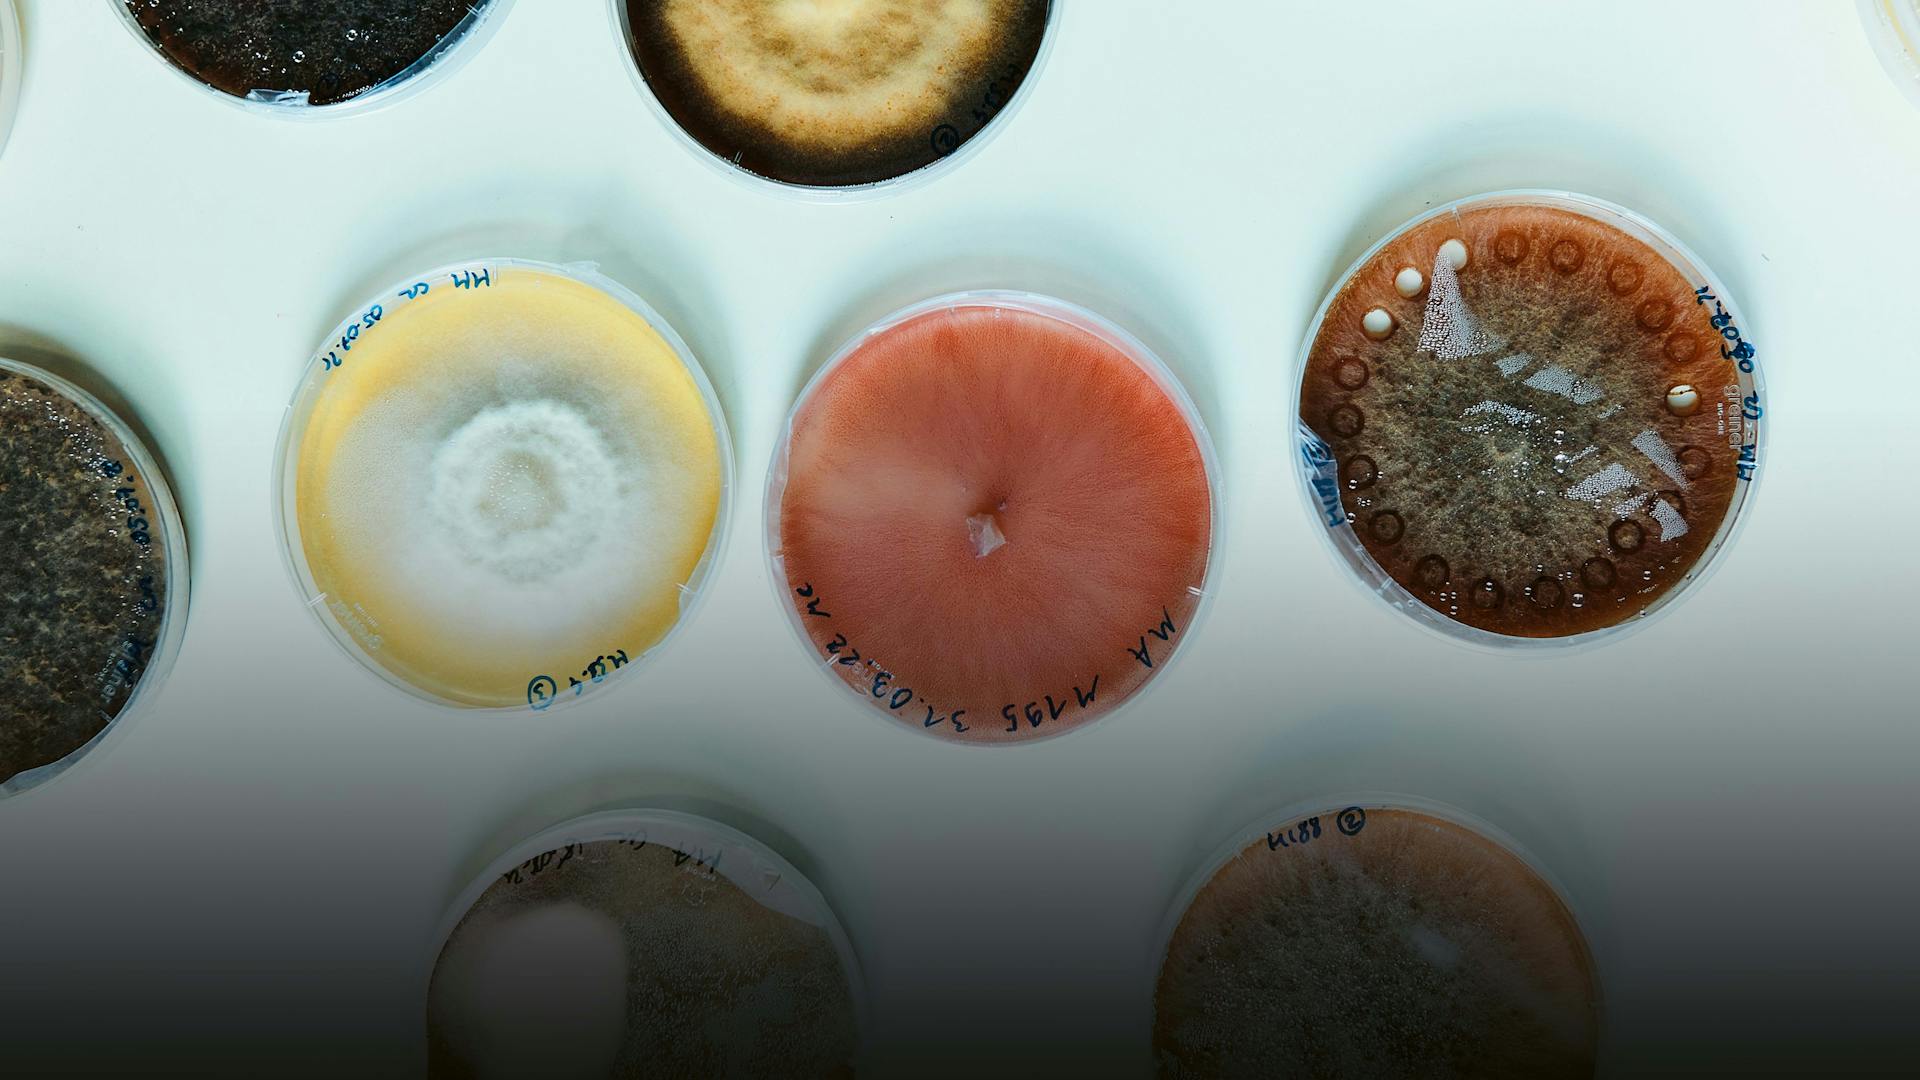
content-image

Live. Magazine



Travels in medicine
Ein Campus Federgewicht.
Der Campus-Falkner
Als Spiegelbild der ursprünglichen Landschaft des Oberrheintals ist der Park auf dem Novartis Campus mit seinem üppigen Blätterdach aus Spitzahorn, Rotbuche und Sandbirken ein Ort der Entspannung, aber leider auch ein Magnet für Krähen und Tauben. Simone Ciluffo und seine abgerichteten Raubvögel schrecken Schwärme von Schadvögeln ab – ein Problem, das während des Lockdowns eskalierte, als Tausende von Krähen und Tauben auf dem Campus sesshaft und zur Gefahr für die Vegetation und die Gebäude wurden.
Text von Penny Ekkert und Jovana Rakovic, Fotos von Alexander Jaquemet und Adriano A. Biondo.
Simone Cilluffo ist einer der wenigen Falkner in der Schweiz. Er besucht mit seinen Vögeln regelmässig den Novartis Campus in Basel. «Wo es die Vorschriften erlauben, kann man die Schadvögel jagen oder fangen, oder aber sie verscheuchen», erklärt er. «Denn Krähen plündern die Nester kleinerer Vögel, während Taubenkot eine Quelle von Parasiten ist und Säuren enthält, die strukturelle Schäden an Gebäuden und Strassen verursachen. Unser Ziel ist es deshalb, die Krähen und die Tauben einzuschüchtern.»

Hier noch Caption.
Cilluffo arbeitet auch oft mit Scirocco, einem Sakerfalken. Scirocco darf über dem Campus schweben und vom Dach abheben. «Sehen die anderen Vögel ihn, erkennen sie die Gefahr und fliegen woanders hin», erklärt Cilluffo.

Hier noch Caption.
Während eines Arbeitstags im Sommer geht Cilluffo mit Janis, einem Wüstenbussard, über den Campus. Janis fliegt von Baum zu Baum, und die Schadvögel fliehen vor dem Raubtier. Cilluffo belohnt Janis mit einem Leckerli für die harte Arbeit.



Cilluffo besitzt eine Reihe von Greifvögeln, darunter auch eine Eule. «Beizvögel sind interessanterweise aktiver als ihre Vettern in freier Wildbahn, die sich nach dem Fressen der gefangenen Beute nicht mehr viel bewegen. Die richtige Ernährung und die Gewichtskontrolle sind ein wichtiger Teil der Arbeit als Falkner.»

IIm Gegensatz zur ursprünglichen Vorgehensweise macht Cilluffo die ganze Arbeit selbst. «Früher kümmerte sich ein ganzes Team um einen Falken: Etwa 15 Personen schwärmten aus, um zu verhindern, dass der Vogel verloren ging. Ich hingegen mache alles selbst: Training, Fütterung, Reinigung, Aufspüren, Pflege der Vögel, wenn sie krank werden.»

Cilluffo verwendet eine Ausrüstung, die sich in den Tausenden von Jahren der Falknerei kaum verändert hat. Ohne GPS-Ortungsgeräte, mit denen es einfacher geworden ist, Vögel wiederzufinden, geht es heute allerdings nicht mehr.


Beim Sturzflug erreicht Scirocco Geschwindigkeiten von bis zu 150 km/h. Entscheidend ist, dass Cilluffo dem Vogel klare Kommandos gibt.

Städtische Landschaften stellen die Falkner und ihre Greifvögel vor spezielle Herausforderungen. «Der Vogel muss hochintelligent sein, damit er sich in städtischen Strukturen zurechtfindet, insbesondere in solchen mit vielen grossen Fenstern wie auf dem Novartis Campus», erläutert Cilluffo.

«Fliegen auf dem Campus ist sehr kompliziert, aber auch spannend. Es ist ein atemberaubend schöner Ort – ich geniesse die Architektur. Eine so attraktive Aufgabe hatte ich noch nie», sagt Cilluffo.
Hören Sie sich die Episode «The Campus falconer» aus der Podcast-Serie How’s your job? an, um mehr über die Arbeit von Simone Cilluffo zu erfahren.